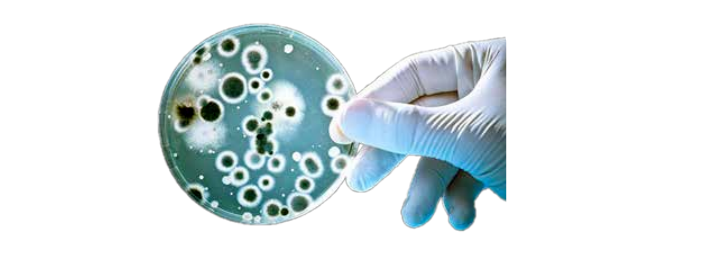
QQ截圖20240826173647.png

潔凈室微生物監測應該遵循什么標準?

ISO 14698第1部分的關鍵原則
危害識別和風險評估
?識別潛在危害:確定可能影響生產過程或產品質量的生物污染源。
?風險評估:評估這些危害發生的可能性,并確定預防或控制措施。
風險區域的指定
?風險區分類:根據污染風險水平對潔凈室內的不同區域進行分類。
?控制措施:實施程序和條件,以消除或減少這些區域內的生物污染機會。
控制限值和監測
?確定控制限值:為每個風險區確定可接受的生物污染水平。
?監測計劃:制定定期監測計劃,以一致地觀察和測量生物污染水平。
糾正措施
?觸發條件:設定條件,一旦滿足,需要立即采取糾正措施。
?糾正程序:實施程序以解決和糾正生物污染事件。
驗證和文件
?驗證程序:建立測試和補充程序,以驗證生物污染控制系統的有效性。
人員培訓
培訓計劃:為潔凈室人員制定和實施培訓計劃,以確保他們了解生物污染控制實踐和程序。
目標
?推廣衛生實踐:確保潔凈室內的所有活動都符合高標準的清潔和衛生。
?最小化污染風險:降低影響生產過程或產品質量的生物污染風險。
?確保合規性:使潔凈室實踐符合國際標準和監管要求。
實施
第2部分:ISO 14698-2:2003為評估和解釋在潔凈室和受控環境中收集的微生物數據的方法提供了指導。這部分標準對于確保生物污染控制措施的有效性以及收集的數據準確反映微生物污染水平至關重要。
微生物數據評估
?目的:提供一種標準化的方法來評估潔凈室的微生物數據。
?方法:描述了估計和解釋活顆粒取樣結果的各種方法。
數據解讀
?指導:就如何解釋微生物數據以評估不同風險區的生物污染水平提供詳細指導。
?應用:確保數據的解釋是一致的,并與ISO 14698-1中概述的控制措施保持一致。
糾正措施和驗證
?觸發條件:定義當生物污染水平超過控制限值時觸發糾正措施的條件。
?核查程序:包括核查生物污染控制措施有效性的程序。
目標
?標準化評估:確保采用一致的方法評估不同潔凈室和受控環境中的微生物數據。
?有效控制:通過為數據評估和解釋提供明確的指導方針,提高生物污染控制措施的有效性。
實施
微生物數據評估
EN17141:200的主要原則和要求
生物污染控制系統
?EN 17141強調實施正式的生物污染控制系統。這包括識別和評估污染源、風險管理以及建立監測計劃,以確保對微生物污染的持續控制。
風險評估
?該標準要求進行徹底的風險評估,以確定潛在的生物污染源,評估污染的可能性和影響,并確定適當的控制措施。這有助于根據潔凈室環境的需求和風險量身定制生物污染策略。
環境監測計劃EN 17141概述了制定詳細環境監測計劃的必要性。該計劃應包括:
?監測位置和頻率
?建立警報和行動限制
?記錄和趨勢數據的文件系統
?對參與監測活動的人員進行培訓和教育微生物測量方法
?該標準為選擇適當的微生物測量方法提供了指導,包括體積空氣取樣、表面取樣和培養基選擇。它強調對這些方法的驗證,以確保準確可靠的數據收集。
控制演示
持續改進
實施
主要優勢